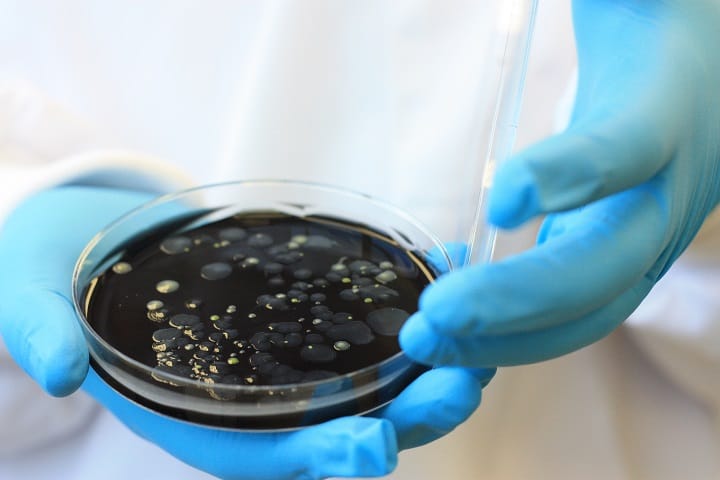

Legionella Detected in UK Leisure Centres – Legionella Risk Grows
Concerns over Legionnaires’ Disease have grown significantly over the past few weeks after many new reports have surfaced across the UK. The disease, which is contracted from Legionella bacteria, is a pneumonia-like lung infection that can develop after inhaling infected water droplets and can prove fatal in some cases. Click here to find out more about Legionella.
Routine tests recently detected the bacteria in a Derbyshire leisure centre, resulting in the closure of the premises until further notice. Andrea Fallon, the director of public health and well-being at Rochdale Council has stated that the risk of contracting the disease at this property is low, nevertheless, users of the pool are still being urged to keep aware of any signs or symptoms.
A more severe case was reported after a man was hospitalized due to contracting the disease from an Essex gym. Health authorities such as HSE (Health and Safety Executive) and RIDDOR (Reporting of injuries, Diseases and Dangerous Occurrences Regulations 2013) were notified and subsequent assessments revealed Legionella was present in the showers.
Managing Legionella
As the owner of a leisure centre, it is a legal requirement to have a Legionella Risk Assessment conducted on your premises. Failure to do so may end in casualities as mentioned above, as well as a heavy fine. Cleartech Group Ltd offer many L8 Compliance services to ensure that you are completely conversant with all regulations.
Cleartech; Your Legionella Compliance Specialist
Cleartech Group Ltd guarantees that clients are fully aware of and in total compliance with all the current Legislation, Codes of Practice & Guidance.
Cleartech is a member of the Legionella Control Association (LCA), and has a highly trained and competent team of City & Guilds qualified L8 Risk Assessors, water treatment engineers and technicians, we deliver L8 Compliance services to meet clients’ needs, on a national basis. This can include full L8 Water Compliance monitoring or just the areas not covered by your own personnel.
To ensure that your business is fully compliant and operating within the law, call us today on 01698 682000, send an email to [email protected] or submit a contact form to our website.